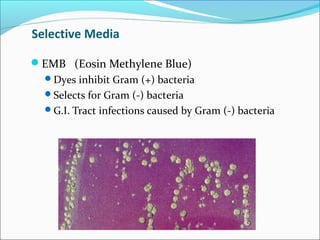
Selective Media 
EMB (Eosin Methylene Blue) 
Dyes inhibit Gram (+) bacteria 
Selects for Gram (-) bacteria 
G.I. Tract infections caused by Gram (-) bacteria
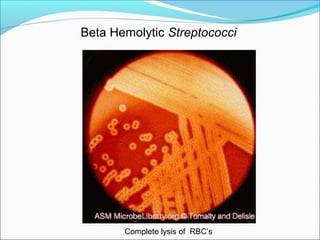
Beta Hemolytic Streptococci 
Complete lysis of RBC’s

This document provides information on microbial culture and growth conditions. It discusses that media provides the necessary nutrients to support microbial growth. Different types of media are used for different purposes, such as general purpose media, enriched media to support fastidious microbes, selective media that inhibits some bacteria, and differential media that distinguishes between organisms. Examples of common media like nutrient agar and specific media like MacConkey agar are described. The document also outlines culture techniques for anaerobic and microaerophilic bacteria that require specialized environments to grow.